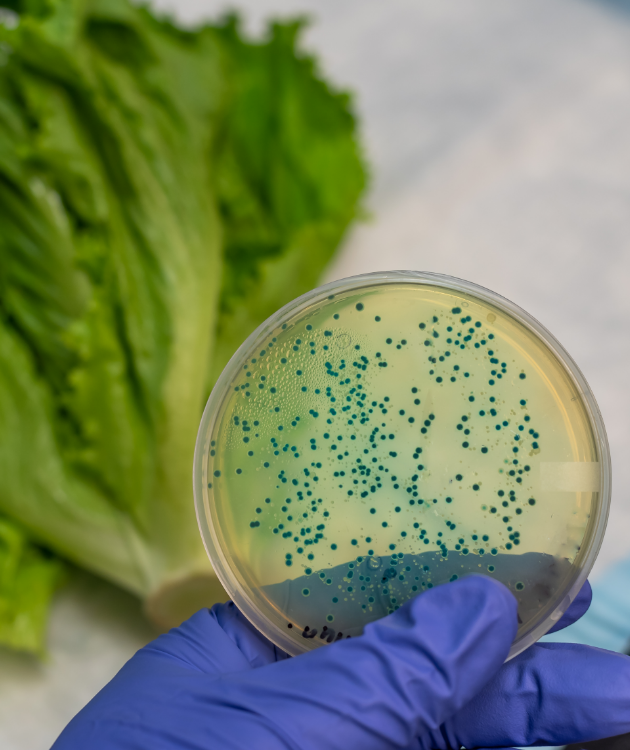

Recall Database Features
Features that minimize food safety risk in the supply chain



Features that minimize food safety risk in the supply chain
Easy access to global food safety recalls from one single database.
Get notified in real time to recall based on the subscription to the risk types.
Receive notifications by email or SMS or InApp when a recall occurs based on the configuration.
Monitor food safety trends and receive customized reports based on commodity and supplier.
Search the recall database with advanced and conditional based search criteria.
Monitor recall happenings around the world in real-time via a centralized, live dashboard
Implement a local regulatory complaint recall plan to manage recall quickly and efficiently.
Test recall efficiency with the configurable Mock recall plan created in the Smart Recall module
Comply with industry regulations during recalls with Smart Recall.
Smart Recall provides user access to the global recall database by populating alerts from various global regulatory sources.

Smart Recall allows users to search the growing list of food recalls and easily find out based on a country, commodity or industry specific risk.

Stay updated about the latest recalls happening across the world with the help of our notification settings.

Get a personalized dashboard based on your recall search. Assess the risks associated with food safety by reviewing the product recall data.

Smart recall will help your organization plan for the three phases of a recall: the discovery of the problem, the recall itself, and the aftermath and follow-up.

Search for recalls by commodity, country of origin or suppliers.
Star the recalls based on your industry to add to favorites
Share your email to receive customized updates on latest recalls as per your search
Instantly receive notifications on latest recalls around the world.
Get a customized dashboard and reporting for analyzing the food safety risks associated with the recalls
Create a mock recall program to plan the recall strategy during the time of incidence.
The process of withdrawing a non compliant product from the market.
Any organization manufacturing or distributing products to the market places are required by the local regulatory authority to have a recall program which would allow the business to withdraw products from the market effectively.
Most of the regulatory authorities publish recalls on their websites. Users can either search the regulatory site or Smart Recall search page to check if an item has been recalled.
Recall notices are often issued by the local regulatory authority directing the business to withdraw the product from the marketplace due to potential food safety concerns.
Our step by step user guide helps businesses to develop a recall program to meet the local regulatory requirements.
Smart Recall not only allows businesses to stay ahead with the food safety risk in the supply chain but also enables the organization to have a recall program which has been tested and verified.
Copyright @ 2025 Smart Farm
Copyright @ 2025 Smart Farm